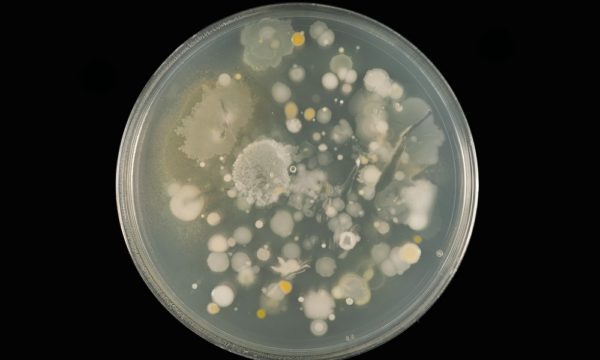

CABI centre: United Kingdom
Scientists at our centre in Egham carry out scientific research, international development projects and microbial services. Over the years its work has supported hundreds of projects and reached thousands of farmers in countries across the world. CABI also has a corporate office in Wallingford.